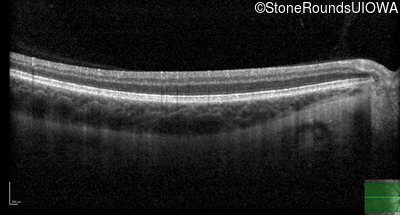
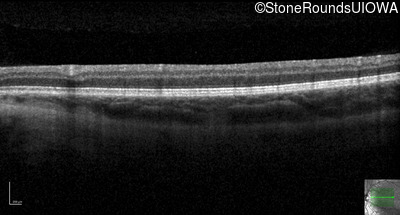
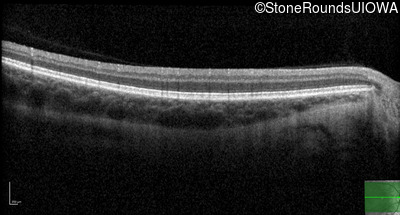
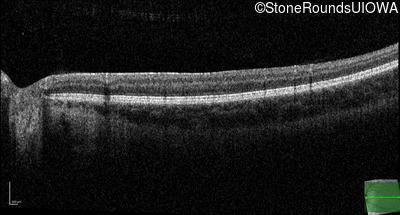

Case
SR1808
Student Mode
AD Optic Neuropathy (IIIC1a)
Female
Female
Hidden
SR1808
Student Mode
AD Optic Neuropathy (IIIC1a)
Female
Female
History
This 29 year old woman was first found to have reduced acuity at age 5 when her parents noticed her sitting very close to the TV and holding books very close to her face to read. She does not think her vision has changed appreciably since she was 5. When she was 6 years old she was able to see 9 out of 14 color plates.
| Age at visit: 26 years |
Diagnosis & molecular findings
| Disease | Gene | Allele 1 variant(s) | Allele 2 variant(s) | Inheritance mode |
|---|---|---|---|---|
| AD Optic Neuropathy | OPA1 | IVS14+1 G>A | AD |